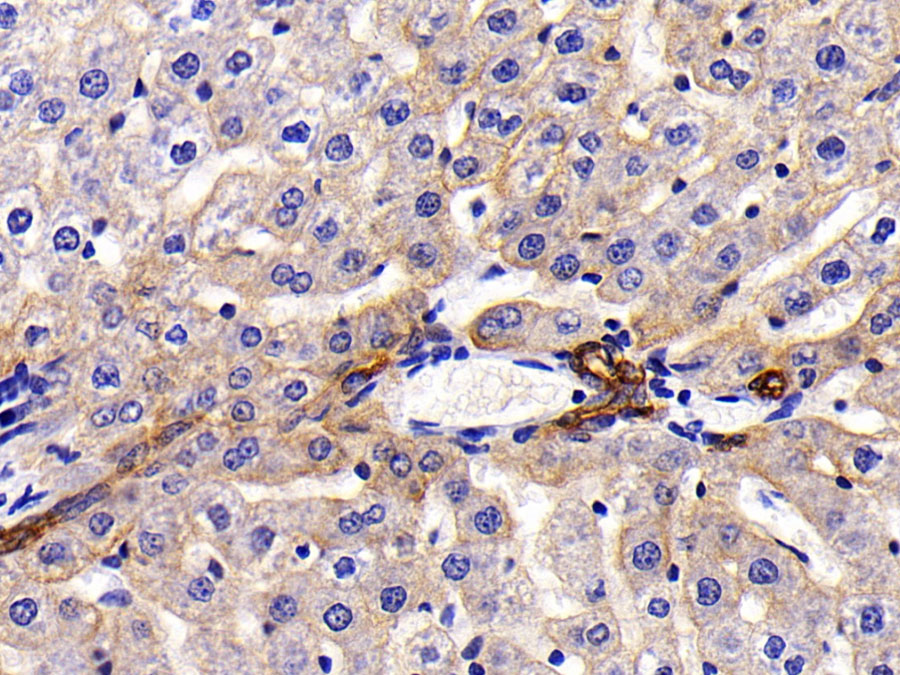

Biotin-Linked Polyclonal Antibody to Retinol Binding Protein 4 (RBP4) 

PRBP; RBP; Plasma retinol-binding protein; Retinol Binding Protein 4, Plasma
- UOM
- FOB US$ 125.00 US$ 291.00 US$ 416.00 US$ 1,040.00 US$ 4,160.00
- Quantity
Overview
Properties
- Product No.LAA929Bo71
- Organism SpeciesBos taurus; Bovine (Cattle) Same name, Different species.
- ApplicationsIHCIf the antibody is used in flow cytometry, please check FCM antibodies.
Research use only - Downloadn/a
- CategoryMetabolic pathwayEndocrinologyHormone metabolism
- SourceAntibody labeling
- Ig Type IgG, Potency n/a
- PurificationAntigen-specific affinity chromatography followed by Protein A affinity chromatography
- LabelBiotin
- Original Antibody n/a
- Buffer Formulation0.01M PBS, pH7.4, containing 0.05% Proclin-300, 50% glycerol.
- TraitsLiquid, Concentration 500µg/mL
Sign into your account
Share a new citation as an author
Upload your experimental result
Review

Contact us
Please fill in the blank.
Specifity
The antibody is a rabbit polyclonal antibody raised against RBP4. It has been selected for its ability to recognize RBP4 in immunohistochemical staining and western blotting.
Usage
Western blotting: 0.2-2µg/mL;1:250-2500
Immunohistochemistry: 5-20µg/mL;1:25-100
Immunocytochemistry: 5-20µg/mL;1:25-100
Optimal working dilutions must be determined by end user.
Storage
Store at 4°C for frequent use. Stored at -20°C in a manual defrost freezer for two year without detectable loss of activity. Avoid repeated freeze-thaw cycles.
Stability
The thermal stability is described by the loss rate. The loss rate was determined by accelerated thermal degradation test, that is, incubate the protein at 37°C for 48h, and no obvious degradation and precipitation were observed. The loss rate is less than 5% within the expiration date under appropriate storage condition.
Organism Species More: Rattus norvegicus (Rat)Giveaways
Increment services
-
 Protein A/G Purification Column
Protein A/G Purification Column
-
 Staining Solution for Cells and Tissue
Staining Solution for Cells and Tissue
-
 Positive Control for Antibody
Positive Control for Antibody
-
 Tissue/Sections Customized Service
Tissue/Sections Customized Service
-
 Phosphorylated Antibody Customized Service
Phosphorylated Antibody Customized Service
-
 Western Blot (WB) Experiment Service
Western Blot (WB) Experiment Service
-
 Immunohistochemistry (IHC) Experiment Service
Immunohistochemistry (IHC) Experiment Service
-
 Immunocytochemistry (ICC) Experiment Service
Immunocytochemistry (ICC) Experiment Service
-
 Flow Cytometry (FCM) Experiment Service
Flow Cytometry (FCM) Experiment Service
-
 Immunoprecipitation (IP) Experiment Service
Immunoprecipitation (IP) Experiment Service
-
 Immunofluorescence (IF) Experiment Service
Immunofluorescence (IF) Experiment Service
-
 Buffer
Buffer
-
 DAB Chromogen Kit
DAB Chromogen Kit
-
 SABC Kit
SABC Kit
-
 Real Time PCR Experimental Service
Real Time PCR Experimental Service
Citations
- Proteomic Identification of Human Urinary Biomarkers in Diabetes Mellitus Type 2 Liebert: 20100078
- Effect of high dose thiamine on the levels of urinary protein biomarkers in diabetes mellitus type 2PubMed: 21130593
- Quercetin Protects against Cadmium-Induced Renal Uric Acid Transport System Alteration and Lipid Metabolism Disorder in RatsPubMed: PMC3368504
- Combined galanin with insulin improves insulin sensitivity of diabetic rat musclesPubmed:24501381
- Central alarin ameliorated insulin resistance of adipocytes in type 2 diabetic ratsPubmed:25240061
- Effect of endogenous galanin on glucose transporter 4 expression in cardiac muscle of type 2 diabetic ratsPubmed:25445608
- Long-term Effect of Ileal Transposition on Adipokine Serum Level in Zucker (Orl)-Lepr fa Fatty RatsPubmed:25697126
- Differentially expressed urinary biomarkers in children with idiopathic nephrotic syndromePubMed: 26351173
- Expression of retinol binding protein 4 and nuclear factor-ÎşB in diabetic rats with atherosclerosis and the intervention effect of pioglitazonePubmed:27446311
- Expression of retinol binding protein 4 and nuclear factor-κB in diabetic rats with atherosclerosisand the intervention effect of pioglitazone.pubmed:27446311
- Application of a new procedure for liquid chromatography/mass spectrometry profiling of plasma amino acid-related metabolites and untargeted shotgun proteomics to identify mechanisms and biomarkers of calcific aortic stenosisS0021967317311858
- Screening for immune-potentiating antigens from hepatocellular carcinoma patients after radiofrequency ablation by serum proteomic analysisPubmed:29386009
- Lack of pronounced changes in the expression of fatty acid handling proteins in adipose tissue and plasma of morbidly obese humansPubmed:29335416
- RBP4 regulates trophoblastic cell proliferation and invasion via the PI3K/AKT signaling pathwayPubmed:30015949
- Relationship between retinol and risk of diabetic retinopathy: a case-control study
- Retinol binding protein 4 abundance in plasma and tissues is related to body fat deposition in cattlePubmed: 31147589
- Potassium supplementation blunts the effects of high salt intake on serum retinol‐binding protein 4 levels in healthy individuals
- Docosahexaenoic acid (DHA), a nutritional supplement, modulates steroid insensitivity in asthma
- The dietary inflammatory index is associated with anti-and pro-inflammatory adipokines in Brazilian schoolchildren33575861
- Pro-and anti-inflammatory adipokines are associated with cardiometabolic risk markers in Brazilian schoolchildren33834274
- Ileal transposition helps to regulate plasma hepatokine levels in obese Zucker (Crl: ZUC (ORL)-Lepr fa) rats33833309
- Biomarkers of cadmium exposure and renal function in estuarine adult villagers34773507